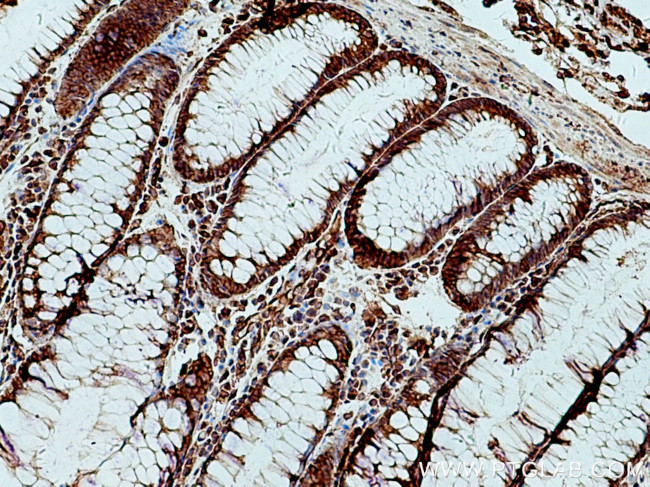
Sec8 Antibody in Immunohistochemistry (Paraffin) (IHC (P))
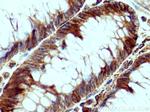
Sec8 Antibody in Immunohistochemistry (Paraffin) (IHC (P))

Search
Proteintech
Sec8 Polyclonal Antibody
{{$productOrderCtrl.translations['antibody.pdp.commerceCard.promotion.promotions']}}
{{$productOrderCtrl.translations['antibody.pdp.commerceCard.promotion.viewpromo']}}
{{$productOrderCtrl.translations['antibody.pdp.commerceCard.promotion.promocode']}}: {{promo.promoCode}} {{promo.promoTitle}} {{promo.promoDescription}}. {{$productOrderCtrl.translations['antibody.pdp.commerceCard.promotion.learnmore']}}
产品信息
11913-1-AP
种属反应
宿主/亚型
分类
类型
抗原
偶联物
形式
浓度
规格
纯化类型
保存液
内含物
保存条件
运输条件
产品详细信息
Immunogen sequence: KHVLNLLDE IENIKQVPQK LEQCMASKHY LSATDMLVSA VESLEGPLLQ VEGLSDLRLE LHSKKMNLHL VLIDELHRHL YIKSTSRVVQ RNKEKGKISS LVKDASVPLI DVTNLPTPRK FLDTSHYSTA GSSSVREINL QDIKEDLELD PEENSTLFMG ILIKGLAKLK KIPETVKAII ERLEQELKQI VKRSTTQVAD SGYQRGENVT VENQPRLLLE LLELLFDKFN AVAAAHSVVL GYLQDTVVTP LTQQEDIKLY DMADVWVKIQ DVLQMLLTEY LDMKNTRTAS EPSAQLSYAS TGREFAAFFA KKKPQRPKNS LFKFESSSHA ISMSAYLREQ RRELYSRSGE LQGE (122-474 aa encoded by B C026174)
靶标信息
The protein encoded by this gene is a component of the exocyst complex, a multiple protein complex essential for targeting exocytic vesicles to specific docking sites on the plasma membrane. Though best characterized in yeast, the component proteins and functions of exocyst complex have been demonstrated to be highly conserved in higher eukaryotes. At least eight components of the exocyst complex, including this protein, are found to interact with the actin cytoskeletal remodeling and vesicle transport machinery. The complex is also essential for the biogenesis of epithelial cell surface polarity. Alternate transcriptional splice variants, encoding different isoforms, have been characterized.
仅用于科研。不用于诊断过程。未经明确授权不得转售。
生物信息学
蛋白别名: augmenter of liver regeneration (ALR) pseudogene; Exocyst complex component 4; Exocyst complex component Sec8; KIAA1699; MGC27170; REC8; rSec8; SEC8; SEC8-like 1; SEC8L1; Sec8p; secretory protein SEC8; unnamed protein product
基因别名: ALR; C78892; EXOC4; KIAA1699; SEC8; SEC8L1; Sec8p
UniProt ID: (Human) Q96A65, (Rat) Q62824, (Mouse) O35382
Entrez Gene ID: (Human) 60412, (Rat) 116654, (Mouse) 20336